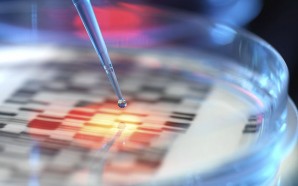

-
Redacción Médica, 10 de noviembre de 2016 Los residentes de ambos modelos formativos coincidirán hasta 2022, cuando solo se quedará la troncalidad La fecha está definida. Los primeros residentes ‘troncales’ se incorporarán en mayo de 2019 al Sistema Nacional de Salud (SNS). Así lo establece el ‘Informe especialización troncal...
-
Redacción Médica, 8 de noviembre e 2016 La matriculación al grado sanitario oscila hasta en 1.600 euros entre las comunidades con la carrera Cumplir el sueño de convertirse en médico será más costoso según donde se cumpla. La variación autonómica en los precios de los créditos del grado sanitario...
-
El Médico Interactivo, 4 de noviembre de 2016 Los hematólogos esperan que Dolors Montserrat sea sensible a la extensión del periodo de formación MIR de la especialidad a cinco años La Sociedad también solicita la participación y asesoramiento del Ministerio en la creación de registros epidemiológicos estatales para las enfermedades hematológicas...
-
Diario Médico, 31 de octubre de 2016 El exvicepresidente del CEEM ha señalado que sólo se permitirá que se alargue la etapa de residencia si está justificado con necesidades formativas. Leonardo Caveda, exvicepresidente del Consejo Estatal de Estudiantes de Medicina (CEEM), señaló que sólo aceptarán que la implementación de...
-
Consalud.es, 31 de octubre de 2016 La comunidad andaluza es la tercera que más plazas oferta después de la Comunidad de Madrid y de Cataluña. Por especialidades, es la región que más oferta en Medicina Familiar y Comunitaria, Enfermería de Salud Mental y matrona. La Consejería de Sanidad de la...
-
Redacción Médica, 28 de octubre de 2016 El ministerio se encargará de acreditar a los profesionales destinados a guiar al MIR El Ministerio de Sanidad reafirma su interés por la recertificación. Específicamente, en el área de los tutores MIR, donde liderarán la entrega y la renovación del diploma de acreditación...
-
Redacción Medica, 28 de octubre de 2016 El 41 por ciento de los encuestados considera la medida de Sanidad como la peor de las últimas convocatorias Rechazo a la penalización por el abandono de plaza MIR. La encuesta online de Redacción Médicarevela que el 41 por ciento de los...
-
Redacción Médica, 26 de octubre de 2016 La propuesta impulsada por decanos y estudiantes de Medicina tiene su primer eco en las autonomías Facilitar el acceso al grado. La Conferencia Nacional de Decanos de Medicina junto con el Consejo Estatal de Estudiantes de Medicina (CEEM) ha propuesto la creación...
-
Redacción Médica, 26 de octubre de 2016 Las disciplinas más demandadas requieren acceder a un número inferior a los 610 puestos Largas horas de estudio, simulacros y trasnochos. Durante meses, los candidatos al MIR se preparan para acceder a la plaza de la especialidad donde realizará la residencia. Sin...